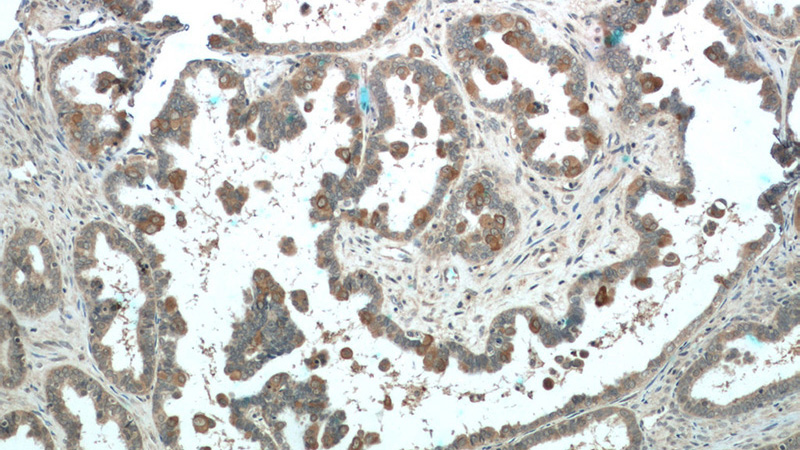
Immunohistochemistry of paraffin-embedded human ovary tumor tissue slide using Catalog No:113665(PDE6A Antibody) at dilution of 1:50 (under 10x lens)
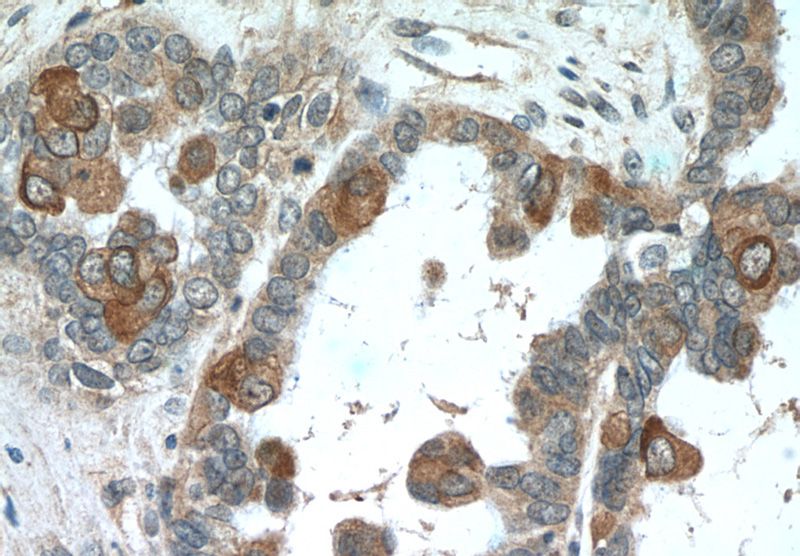
Immunohistochemistry of paraffin-embedded human ovary tumor tissue slide using Catalog No:113665(PDE6A Antibody) at dilution of 1:50 (under 40x lens)

-
Product Name
PDE6A antibody
- Documents
-
Description
PDE6A Rabbit Polyclonal antibody. Positive WB detected in human brain tissue, HEK-293 cells, mouse eye tissue. Positive IHC detected in human ovary tumor tissue, human colon cancer tissue. Positive IF detected in retinal tissue. Observed molecular weight by Western-blot: 100-110 kDa
-
Tested applications
ELISA, WB, IF, IHC
-
Species reactivity
Human,Mouse,Rat; other species not tested.
-
Alternative names
CGPR A antibody; GMP PDE alpha antibody; PDE V B1 antibody; PDE6 alpha antibody; PDE6A antibody; PDEA antibody
-
Isotype
Rabbit IgG
-
Preparation
This antibody was obtained by immunization of PDE6A recombinant protein (Accession Number: NM_000440). Purification method: Antigen affinity purified.
-
Clonality
Polyclonal
-
Formulation
PBS with 0.02% sodium azide and 50% glycerol pH 7.3.
-
Storage instructions
Store at -20℃. DO NOT ALIQUOT
-
Applications
Recommended Dilution:
WB: 1:200-1:2000
IHC: 1:20-1:200
IF: N/A
-
Validations

WB results of PDE6A antibody (Catalog No:113665) with WT mouse Eye and Prph2 (Rds) mutant mouse Eye (Negative control). Courtesy of Seongjin Seo, PhD, University of Iowa College of Medicine.

IF stain of PDE6a antibody with retinal tissue by a customer. (PDE6a is in red and nuclei are blue).

human brain tissue were subjected to SDS PAGE followed by western blot with Catalog No:113665(PDE6A antibody) at dilution of 1:500
Immunohistochemistry of paraffin-embedded human ovary tumor tissue slide using Catalog No:113665(PDE6A Antibody) at dilution of 1:50 (under 10x lens)
Immunohistochemistry of paraffin-embedded human ovary tumor tissue slide using Catalog No:113665(PDE6A Antibody) at dilution of 1:50 (under 40x lens)
-
Background
PDE6A(Rod cGMP-specific 3',5'-cyclic phosphodiesterase subunit alpha) is also named as GMP-PDE alpha, PDE V-B1, PDEA and belongs to the cyclic nucleotide phosphodiesterase family. PDE6A contains an open reading frame capable of coding for a polypeptide of 859 amino acids and about 100 kDa. It is a subunit of a key phototransduction enzyme which participates in processes of transmission and amplification of the visual signal. The expression of PDE6 alpha in retina is essential for normal expression of PDE6 beta and PDE6 gama.
-
References
- Datta P, Allamargot C, Hudson JS. Accumulation of non-outer segment proteins in the outer segment underlies photoreceptor degeneration in Bardet-Biedl syndrome. Proceedings of the National Academy of Sciences of the United States of America. 112(32):E4400-9. 2015.
Related Products / Services
Please note: All products are "FOR RESEARCH USE ONLY AND ARE NOT INTENDED FOR DIAGNOSTIC OR THERAPEUTIC USE"
